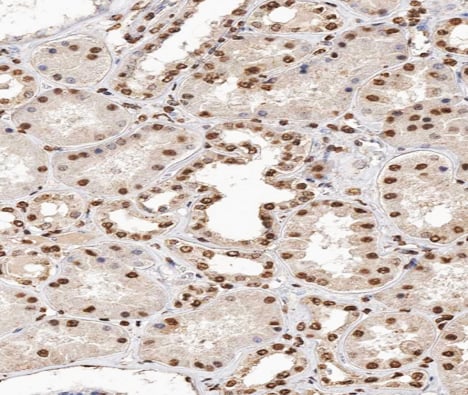
product-image-AAA321743_IHC15.jpg

Rabbit p38 MAPK Polyclonal Antibody | anti-MAPK14 antibody
Phospho-p38 MAPK (Tyr182) Antibody
Phosphate buffered saline, pH 7.4, 150mM NaCl, 0.02% sodium azide and 50% glycerol.
WB (Western Blot)
(Western blot analysis of Phospho-p38 MAPK (Tyr182) expression in various lysates)
WB (Western Blot)
(Western blot analysis of p38 MAPK phosphorylation expression in K562 whole cell lysates, The lane on the left is treated with the antigen-specific peptide.)
IF (Immunofluorescence)
(AAA321743 staining Hela by IF/ICC. The sample were fixed with PFA and permeabilized in 0.1% Triton X-100, then blocked in 10% serum for 45 minutes at 25 degree C. The primary antibody was diluted at 1/200 and incubated with the sample for 1 hour at 37 degree C. An Alexa Fluor 594 conjugated goat anti-rabbit IgG (H+L) Ab, diluted at 1/600, was used as the secondary antibody.)
IHC (Immunohistochemistry)
(AAA321743 at 1/200 staining human kidney tissue sections by IHC-P. The tissue was formaldehyde fixed and a heat mediated antigen retrieval step in citrate buffer was performed. The tissue was then blocked and incubated with the antibody for 1.5 hours at 22 degree C. An HRP conjugated goat anti-rabbit antibody was used as the secondary.)
Function: Serine/threonine kinase which acts as an essential component of the MAP kinase signal transduction pathway. MAPK14 is one of the four p38 MAPKs which play an important role in the cascades of cellular responses evoked by extracellular stimuli such as proinflammatory cytokines or physical stress leading to direct activation of transcription factors. Accordingly, p38 MAPKs phosphorylate a broad range of proteins and it has been estimated that they may have approximately 200 to 300 substrates each. Some of the targets are downstream kinases which are activated through phosphorylation and further phosphorylate additional targets. RPS6KA5/MSK1 and RPS6KA4/MSK2 can directly phosphorylate and activate transcription factors such as CREB1, ATF1, the NF-kappa-B isoform RELA/NFKB3, STAT1 and STAT3, but can also phosphorylate histone H3 and the nucleosomal protein HMGN1. RPS6KA5/MSK1 and RPS6KA4/MSK2 play important roles in the rapid induction of immediate-early genes in response to stress or mitogenic stimuli, either by inducing chromatin remodeling or by recruiting the transcription machinery. On the other hand, two other kinase targets, MAPKAPK2/MK2 and MAPKAPK3/MK3, participate in the control of gene expression mostly at the post-transcriptional level, by phosphorylating ZFP36 (tristetraprolin) and ELAVL1, and by regulating EEF2K, which is important for the elongation of mRNA during translation. MKNK1/MNK1 and MKNK2/MNK2, two other kinases activated by p38 MAPKs, regulate protein synthesis by phosphorylating the initiation factor EIF4E2. MAPK14 interacts also with casein kinase II, leading to its activation through autophosphorylation and further phosphorylation of TP53/p53. In the cytoplasm, the p38 MAPK pathway is an important regulator of protein turnover. For example, CFLAR is an inhibitor of TNF-induced apoptosis whose proteasome-mediated degradation is regulated by p38 MAPK phosphorylation. In a similar way, MAPK14 phosphorylates the ubiquitin ligase SIAH2, regulating its activity towards EGLN3. MAPK14 may also inhibit the lysosomal degradation pathway of autophagy by interfering with the intracellular trafficking of the transmembrane protein ATG9. Another function of MAPK14 is to regulate the endocytosis of membrane receptors by different mechanisms that impinge on the small GTPase RAB5A. In addition, clathrin-mediated EGFR internalization induced by inflammatory cytokines and UV irradiation depends on MAPK14-mediated phosphorylation of EGFR itself as well as of RAB5A effectors. Ectodomain shedding of transmembrane proteins is regulated by p38 MAPKs as well. In response to inflammatory stimuli, p38 MAPKs phosphorylate the membrane-associated metalloprotease ADAM17. Such phosphorylation is required for ADAM17-mediated ectodomain shedding of TGF-alpha family ligands, which results in the activation of EGFR signaling and cell proliferation. Another p38 MAPK substrate is FGFR1. FGFR1 can be translocated from the extracellular space into the cytosol and nucleus of target cells, and regulates processes such as rRNA synthesis and cell growth. FGFR1 translocation requires p38 MAPK activation. In the nucleus, many transcription factors are phosphorylated and activated by p38 MAPKs in response to different stimuli. Classical examples include ATF1, ATF2, ATF6, ELK1, PTPRH, DDIT3, TP53/p53 and MEF2C and MEF2A. The p38 MAPKs are emerging as important modulators of gene expression by regulating chromatin modifiers and remodelers. The promoters of several genes involved in the inflammatory response, such as IL6, IL8 and IL12B, display a p38 MAPK-dependent enrichment of histone H3 phosphorylation on 'Ser-10' (H3S10ph) in LPS-stimulated myeloid cells. This phosphorylation enhances the accessibility of the cryptic NF-kappa-B-binding sites marking promoters for increased NF-kappa-B recruitment. Phosphorylates CDC25B and CDC25C which is required for binding to 14-3-3 proteins and leads to initiation of a G2 delay after ultraviolet radiation. Phosphorylates TIAR following DNA damage, releasing TIAR from GADD45A mRNA and preventing mRNA degradation. The p38 MAPKs may also have kinase-independent roles, which are thought to be due to the binding to targets in the absence of phosphorylation. Protein O-Glc-N-acylation catalyzed by the OGT is regulated by MAPK14, and, although OGT does not seem to be phosphorylated by MAPK14, their interaction increases upon MAPK14 activation induced by glucose deprivation. This interaction may regulate OGT activity by recruiting it to specific targets such as neurofilament H, stimulating its O-Glc-N-acylation. Required in mid-fetal development for the growth of embryo-derived blood vessels in the labyrinth layer of the placenta. Also plays an essential role in developmental and stress-induced erythropoiesis, through regulation of EPO gene expression. Isoform MXI2 activation is stimulated by mitogens and oxidative stress and only poorly phosphorylates ELK1 and ATF2. Isoform EXIP may play a role in the early onset of apoptosis. Phosphorylates S100A9 at 'Thr-113'.
Subunit Structure: Component of a signaling complex containing at least AKAP13, PKN1, MAPK14, ZAK and MAP2K3. Within this complex, AKAP13 interacts directly with PKN1, which in turn recruits MAPK14, MAP2K3 and ZAK (PubMed:21224381). Binds to a kinase interaction motif within the protein tyrosine phosphatase, PTPRR (By similarity). This interaction retains MAPK14 in the cytoplasm and prevents nuclear accumulation (By similarity). Interacts with SPAG9 and GADD45A (By similarity). Interacts with CDC25B, CDC25C, DUSP1, DUSP10, DUSP16, NP60, SUPT20H and TAB1. Interacts with casein kinase II subunits CSNK2A1 and CSNK2B. Interacts with PPM1D. Interacts with CDK5RAP3; recruits PPM1D to MAPK14 and may regulate its dephosphorylation (PubMed:21283629).
Post-translational Modifications: Dually phosphorylated on Thr-180 and Tyr-182 by the MAP2Ks MAP2K3/MKK3, MAP2K4/MKK4 and MAP2K6/MKK6 in response to inflammatory citokines, environmental stress or growth factors, which activates the enzyme. Dual phosphorylation can also be mediated by TAB1-mediated autophosphorylation. TCR engagement in T-cells also leads to Tyr-323 phosphorylation by ZAP70. Dephosphorylated and inactivated by DUPS1, DUSP10 and DUSP16. PPM1D also mediates dephosphorylation and inactivation of MAPK14 (PubMed:21283629). Acetylated at Lys-53 and Lys-152 by KAT2B and EP300. Acetylation at Lys-53 increases the affinity for ATP and enhances kinase activity. Lys-53 and Lys-152 are deacetylated by HDAC3. Ubiquitinated. Ubiquitination leads to degradation by the proteasome pathway.
Similarity: The TXY motif contains the threonine and tyrosine residues whose phosphorylation activates the MAP kinases. Belongs to the protein kinase superfamily. CMGC Ser/Thr protein kinase family. MAP kinase subfamily.
NCBI and Uniprot Product Information
Predicted: 42 kDa
Customer Reviews
Loading reviews...
Share Your Experience
Similar Products
Product Notes
The MAPK14 mapk14 (Catalog #AAA321743) is an Antibody produced from Rabbit and is intended for research purposes only. The product is available for immediate purchase. The Phospho-p38 MAPK (Tyr182) Antibody reacts with Human, Mouse, Rat and may cross-react with other species as described in the data sheet. AAA Biotech's p38 MAPK can be used in a range of immunoassay formats including, but not limited to, ELISA, ICC (Immunocytochemistry), IF (Immunofluorescence), IHC (Immunohistochemistry), WB (Western Blot). Researchers should empirically determine the suitability of the MAPK14 mapk14 for an application not listed in the data sheet. Researchers commonly develop new applications and it is an integral, important part of the investigative research process. It is sometimes possible for the material contained within the vial of "p38 MAPK, Polyclonal Antibody" to become dispersed throughout the inside of the vial, particularly around the seal of said vial, during shipment and storage. We always suggest centrifuging these vials to consolidate all of the liquid away from the lid and to the bottom of the vial prior to opening. Please be advised that certain products may require dry ice for shipping and that, if this is the case, an additional dry ice fee may also be required.Precautions
All products in the AAA Biotech catalog are strictly for research-use only, and are absolutely not suitable for use in any sort of medical, therapeutic, prophylactic, in-vivo, or diagnostic capacity. By purchasing a product from AAA Biotech, you are explicitly certifying that said products will be properly tested and used in line with industry standard. AAA Biotech and its authorized distribution partners reserve the right to refuse to fulfill any order if we have any indication that a purchaser may be intending to use a product outside of our accepted criteria.Disclaimer
Though we do strive to guarantee the information represented in this datasheet, AAA Biotech cannot be held responsible for any oversights or imprecisions. AAA Biotech reserves the right to adjust any aspect of this datasheet at any time and without notice. It is the responsibility of the customer to inform AAA Biotech of any product performance issues observed or experienced within 30 days of receipt of said product. To see additional details on this or any of our other policies, please see our Terms & Conditions page.Item has been added to Shopping Cart
If you are ready to order, navigate to Shopping Cart and get ready to checkout.